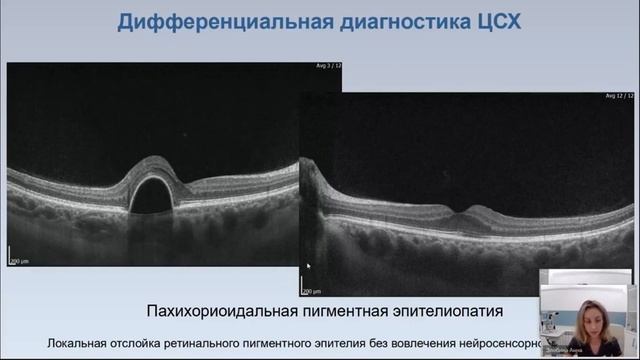
Центральная серозная хориоретинопатия

Новое видео
Расчет ИОЛ и оптимизация констант: Точность которая открывает новые возможности

Видео: Расчет ИОЛ и оптимизация констант: Точность которая открывает новые возможности
Вебинар от офтальмолога Атаманенко А.А. Вебинар посвящён точным расчётам интраокулярных линз.,
Комментарии ( 0
)
Сначала новые
Сначала старые
Сначала лучшие
Загружено по ссылке
Присоединяйтесь к обсуждению
М
Гость
М
Гость
О, Боже, спаси Египет! Спаси Голден файв парадайз! Это был Райский уголок! Счастливая - я была там в 2013 году! Плачу и молюсь...
М
Гость
Вопрос автору где это снято я тоже виделатакое же явление в районе мытищи, Манюхино
М
Гость
2026-04-20 в 22:45:43
2026-04-20 в 22:32:53
2026-04-20 в 22:14:54
2026-04-20 в 22:48:44
2026-04-20 в 22:18:08
2025-11-07 в 12:11:54
2026-04-20 в 22:41:13
2026-04-20 в 22:20:00
2025-11-07 в 12:03:27